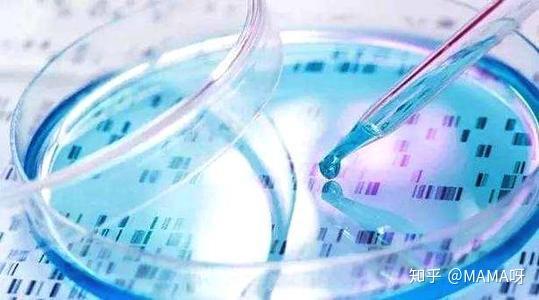

做试管婴儿竟变成人工受孕,男子:成功率高
做试管婴儿竟变成人工受孕,男子:成功率高
587x347 - 13KB - JPEG
 做试管婴儿竟变成人工受孕,男子:成功率高
做试管婴儿竟变成人工受孕,男子:成功率高
550x350 - 32KB - JPEG
男性不育的救命稻草,供精试管婴儿成功率
男性不育的救命稻草,供精试管婴儿成功率
539x300 - 40KB - JPEG
 邓文迪:一个普通女人的逆袭之路
邓文迪:一个普通女人的逆袭之路
400x304 - 27KB - JPEG
 拥有沙雕父母,为什么令人羡慕?
拥有沙雕父母,为什么令人羡慕?
640x337 - 25KB - JPEG
 邓文迪:一个普通女人的逆袭之路
邓文迪:一个普通女人的逆袭之路
400x506 - 33KB - JPEG
李玟自曝正在备孕,尝试打针促进排卵,为了
590x534 - 38KB - JPEG
 漂洋过海来看你苏芒的孩子生下来没苏芒
漂洋过海来看你苏芒的孩子生下来没苏芒
539x400 - 361KB - PNG
 漂洋过海来看你郑楚第几集知道苏芒的孩子
漂洋过海来看你郑楚第几集知道苏芒的孩子
497x326 - 27KB - JPEG
 漂洋过海来看你苏芒孩子是郑楚的吗漂洋
漂洋过海来看你苏芒孩子是郑楚的吗漂洋
500x333 - 24KB - JPEG
 妈妈被强迫受精无水印_强迫交易罪_强迫
妈妈被强迫受精无水印_强迫交易罪_强迫
300x300 - 86KB - JPEG
 漂洋过海来看你苏芒的孩子生下来没 是谁
漂洋过海来看你苏芒的孩子生下来没 是谁
539x400 - 844KB - PNG
 刘弗陵之子-野史秘闻-就爱阅读网
刘弗陵之子-野史秘闻-就爱阅读网
390x480 - 89KB - JPEG
 广州好孕宝贝国际代孕机构
广州好孕宝贝国际代孕机构
423x296 - 35KB - JPEG
 漂洋过海来看你郑楚第几集知道苏芒的孩子
漂洋过海来看你郑楚第几集知道苏芒的孩子
497x326 - 80KB - GIF